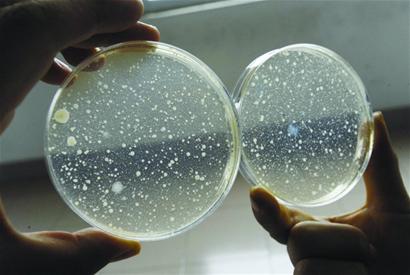

近期,太原市某知名小区居民反映,从去年入住该小区以来,家中自来水就散发出严重异味,无法正常使用,虽向物业多次反映,但水质问题一直没有得到解决。7月1日,经太原市晋源区卫生局卫生监督所委托监测,水质不符合《生活饮用水卫生标准》。其中,18层住户自来水菌落总数高达2100CFU/mL,而我国在水质常规指标限值中,菌落总数上限为100CFU/mL,超过上限近20倍。

一、自来水异味严重
该小区某居民表示:“都不用凑近闻,开一会儿水,整个屋子都会弥漫这种油漆混杂着化学气体的味道,闻多了会头晕。”而这种情况则持续了半年之久。
同时,有多位业主提出:“水的味道太大不敢喝,现在也根本不敢给孩子用,洗个澡还得去公共浴池,我们花这么多钱买的房子,还得每天担心健康问题。”
二、菌落总数超标
晋源区卫生局卫生监督所委托检验的《国家城市供水水质监测网太原监测站检验报告》显示,该小区进水点取样水所检项目符合《生活饮用水卫生标准》,而在居民家中两处取样送样检测项目中,臭和味、菌落总数、游离余氯检测项目结果均不合格《生活饮用水卫生标准》GB5749-2006。
其中,臭和味项目结果均为“5级,很强异味”;菌落总数项目检查结果,18层送样高达2100CFU/mL,19层为970CFU/mL,而我国在水质常规指标限值中,菌落总数上限为100CFU/mL,居民家中自来水菌落总数远超国家标准。

三、物业三缄其口
面对此事,该小区物业已开始向有需求的业主免费供应桶装饮用水,并和业主协商共同委托专业机构对小区水质进行检测。而对于小区水质检测为何不合格和为何居民反映半年之久未进行水质检测的问题,物业管理负责人却不愿多做回答。
Safety of water quality
如何更好地保障自家的饮水安全?
所以说,靠天靠地不如靠自己,房子买的再好,饮水的洁净与健康却保障不了,一切也是白搭。
当前,城市高楼林立,有相当比例的供水管道陈旧老化,相关房产部门管材属禁用、限用的管道占一定的比例,楼宇二次加压导致自来水在这些管线内滞留的时间越长,二次污染程度就越高,为消除后顾之忧,市民不如给自家安装个净水器。

净水器有不少优点,比如:
-
分质供水,把饮用水和生活水彻底分开,废水可回收利用,节约水资源;
-
量体裁衣,结合家庭实况,给不同需求的家庭设计、选择和定做最适合的设备;
-
物理过滤,利用膜分离技术,安全高效地除去细菌病毒,保留有益微量元素和矿物质;
-
即开即饮,帮您把纯净水厂搬回了家,供应新鲜及时;
-
使用寿命长,一次投资,受益良久,更加经济实惠。
你家水质还好吗?保障安全饮水,净水器家庭必备!有需要可留言联系,或者拨打我们全国统一服务热线:400-830-8885。
